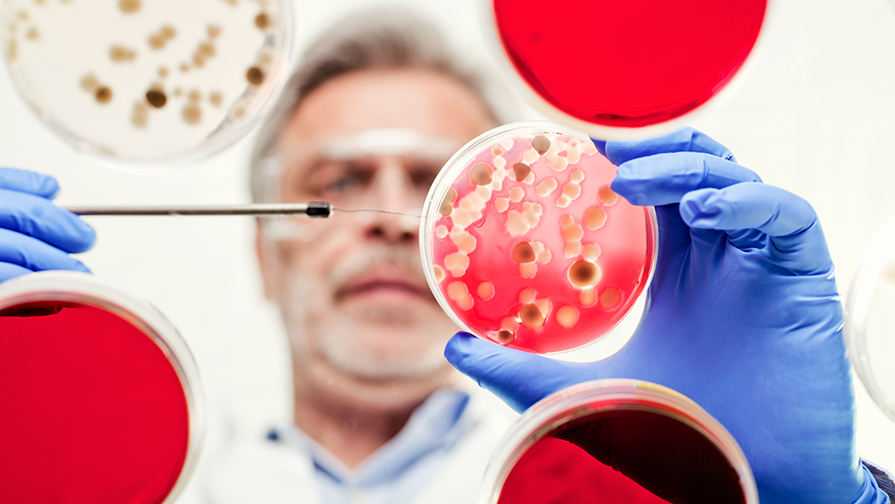
Food Microbiology division

Food Microbiology Division
Quick Information and links
| Chairperson | Login IFT Connect | Not a Member Yet? | Social |
|---|---|---|---|
| Xiaonan Lu | Food Microbiology Division |
Sign Up & Join Us Online |  |

1300+
Division Members
1975
Year Founded
60+
Countries Represented by MembersDivision Oral Competition Finalists
- First: Ana Leticia de Almeida, University of Connecticut: Efficacy of Ultrafine Ozone Bubbles in Inactivating Listeria Monocytogenes, Salmonella spp., and Escherichia Coli O157:H7 in Agricultural Water
- Second: Yihan He, McGill University: Longitudinal and Cross-Sectional Sampling and Whole Genome Sequencing of Campylobacter in a Chicken Abattoir Reveals a Highly Dynamic Population Structure
- Third: Shivaprasad Doddabematti Prakash, Kansas State University: Harnessing Cold Plasma for Salmonella Reduction in Pizza Dough: A Hurdle Technology Approach
Upcoming Events
Northern California Section IFT (NCIFT) Suppliers Night
Pleasanton, California
Maryland Section IFT Suppliers Night
Owings Mills, Maryland
Top